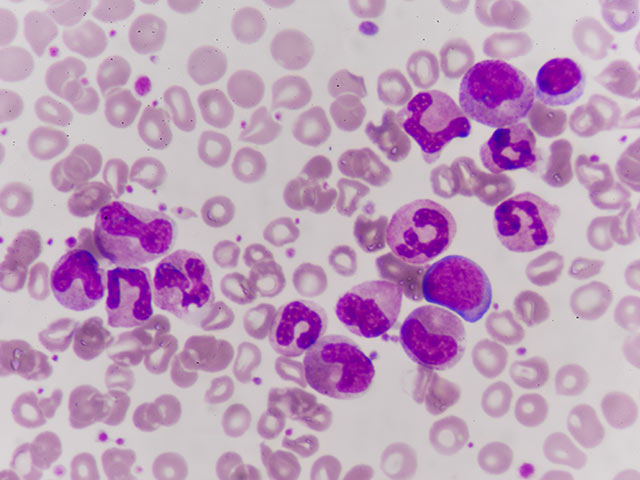
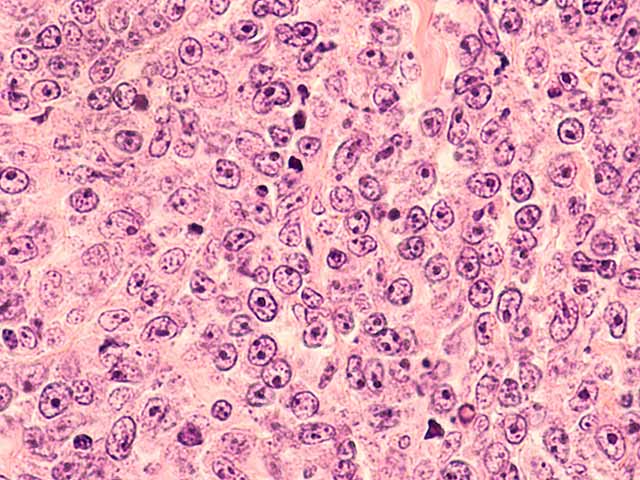

One in five people worldwide develop cancer during their lifetime. Prevention of cancer has become one of the most significant public health challenges of the 21st century. It has a critical role to play in the fight against cancer. Based on current scientific evidence, at least 40% of all cancer cases could be prevented with effective primary prevention measures, and further mortality can be reduced through early detection of tumours.
This feature presents selected content from the IARC website for recent years, including news items, press releases, videos, etc.
CountryView content by Country
A
B
C
D
E
F
G
H
I
J
K
L
M
N
O
P
Q
R
S
T
U
V
Y
Z
View content by Cancer Type
View content by Risk Factor
This page shows selected content only. For more information, please use the search function.